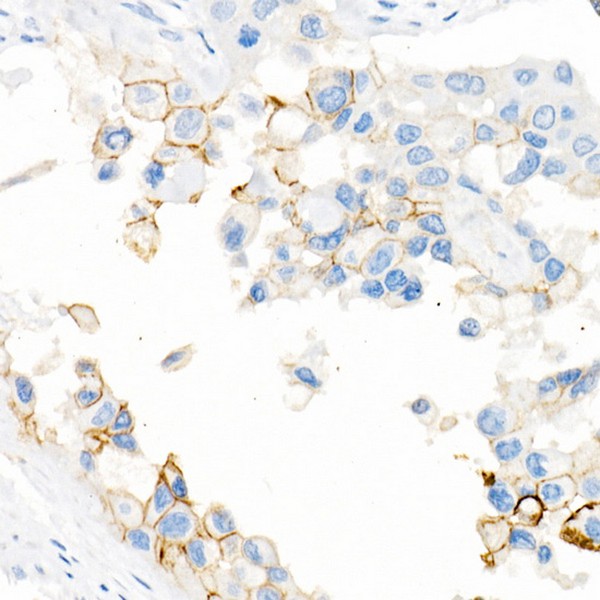
Abclonal CD141/Thrombomodulin Rabbit mAb (Catalog Number: A21238)

CD141/Thrombomodulin Rabbit mAb (A21238)
$148.00 – $548.00
Abclonal CD141/Thrombomodulin Rabbit mAb (Catalog Number: A21238) encoded by this intronless gene is an endothelial-specific type I membrane receptor that binds thrombin.
- Details & Specifications
- References
| Catalog No. | A21238 |
|---|---|
| Product Name | CD141/Thrombomodulin Rabbit mAb (A21238) |
| Supplier Name | ABclonal, Inc. |
| Brand Name | Abclonal |
| Synonyms | TM; THRM; AHUS6; BDCA3; CD141; BDCA-3; THPH12 |
| Gene Name | THBD |
| Protein Name | THBD |
| Uniprot/Swissprot ID | P07204 |
| Gene ID | 7056 |
| Clone | ARC52600 |
| Clonality | Monoclonal |
| Source/Host | Rabbit |
| Reactivity | Human |
| Conjugate | Unconjugated |
| Note | Products will be shipped from the warehouse in Massachusetts. Promotion is running from time to time. Welcome to send a request for quote to message@sydlabs.com. |
| Order Offline | Syd Labs, Inc. 4 Avenue E, Hopkinton, MA 01748 USA. Phone: 1-617-401-8149 Fax: 1-617-606-5019 Email: message@sydlabs.com |
Description
A21238: CD141/Thrombomodulin Rabbit mAb
The protein encoded by this intronless gene is an endothelial-specific type I membrane receptor that binds thrombin. This binding results in the activation of protein C, which degrades clotting factors Va and VIIIa and reduces the amount of thrombin generated. Mutations in this gene are a cause of thromboembolic disease, also known as inherited thrombophilia.
Immunogen Information about CD141/Thrombomodulin Rabbit mAb (A21238)
Immunogen:Recombinant fusion protein containing a sequence corresponding to amino acids 19-515 of human CD141/Thrombomodulin (NP_000352.1).
Sequence:APAEPQPGGSQCVEHDCFALYPGPATFLNASQICDGLRGHLMTVRSSVAADVISLLLNGDGGVGRRRLWIGLQLPPGCGDPKRLGPLRGFQWVTGDNNTSYSRWARLDLNGAPLCGPLCVAVSAAEATVPSEPIWEEQQCEVKADGFLCEFHFPATCRPLAVEPGAAAAAVSITYGTPFAARGADFQALPVGSSAAVAPLGLQLMCTAPPGAVQGHWAREAPGAWDCSVENGGCEHACNAIPGAPRCQCPAGAALQADGRSCTASATQSCNDLCEHFCVPNPDQPGSYSCMCETGYRLAADQHRCEDVDDCILEPSPCPQRCVNTQGGFECHCYPNYDLVDGECVEPVDPCFRANCEYQCQPLNQTSYLCVCAEGFAPIPHEPHRCQMFCNQTACPADCDPNTQASCECPEGYILDDGFICTDIDECENGGFCSGVCHNLPGTFECICGPDSALARHIGTDCDSGKVDGGDSGSGEPPPSPTPGSTLTPPAVGLVHS
Gene ID:7056
Swiss prot:P07204
Synonyms:TM; THRM; AHUS6; BDCA3; CD141; BDCA-3; THPH12; CD141/Thrombomodulin
Calculated MW:60kDa
Observed MW:Refer to figures
Images of CD141/Thrombomodulin Rabbit mAb (A21238)

Immunohistochemistry analysis of CD141/Thrombomodulin in paraffin-embedded human lung squamous carcinoma tissue using CD141/Thrombomodulin Rabbit mAb (A21238) at dilution of 1:1000 (40x lens).Perform high pressure antigen retrieval with 10 mM citrate buffer pH 6.0 before commencing with IHC staining protocol.

Immunohistochemistry analysis of CD141/Thrombomodulin in paraffin-embedded human lung using CD141/Thrombomodulin Rabbit mAb (A21238) at dilution of 1:1000 (40x lens).Perform high pressure antigen retrieval with 10 mM citrate buffer pH 6.0 before commencing with IHC staining protocol.

Immunohistochemistry analysis of CD141/Thrombomodulin in paraffin-embedded human tonsil using CD141/Thrombomodulin Rabbit mAb (A21238) at dilution of 1:1000 (40x lens).Perform high pressure antigen retrieval with 10 mM citrate buffer pH 6.0 before commencing with IHC staining protocol.

Immunohistochemistry analysis of CD141/Thrombomodulin in paraffin-embedded human urothelial carcinoma using CD141/Thrombomodulin Rabbit mAb (A21238) at dilution of 1:1000 (40x lens).Perform high pressure antigen retrieval with 10 mM citrate buffer pH 6.0 before commencing with IHC staining protocol.

Immunofluorescence analysis of A431 cells using CD141/Thrombomodulin Rabbit mAb (A21238) at dilution of 1:100 (40x lens). Secondary antibody: Cy3 Goat Anti-Rabbit IgG (H+L) (AS007) at 1:500 dilution. Blue: DAPI for nuclear staining.

Immunofluorescence analysis of THP-1 cells using CD141/Thrombomodulin Rabbit mAb (A21238) at dilution of 1:100 (40x lens). Secondary antibody: Cy3 Goat Anti-Rabbit IgG (H+L) (AS007) at 1:500 dilution. Blue: DAPI for nuclear staining.

Flow cytometry: 1X10^6 Jurkat cells (negative control, left) and THP-1 cells (right) were surface-stained with CD141/Thrombomodulin Rabbit mAb (A21238, 2.5 μg/mL, orange line) or ABflo® 647 Rabbit IgG isotype control (A22070, 5 μl/Test, blue line), followed by Alexa Fluor® 647 conjugated goat anti-rabbit pAb staining. Non-fluorescently stained cells were used as blank control (red line).

Flow cytometry: 1X10^6 THP-1 cells were surface-stained with ABflo® 647 Rabbit IgG isotype control (A22070, 5 μl/Test, left) or CD141/Thrombomodulin Rabbit mAb (A21238, 2.5 μg/mL, right).
Please remember our product information: CD141/Thrombomodulin Rabbit mAb (Catalog Number: A21238) Abclonal